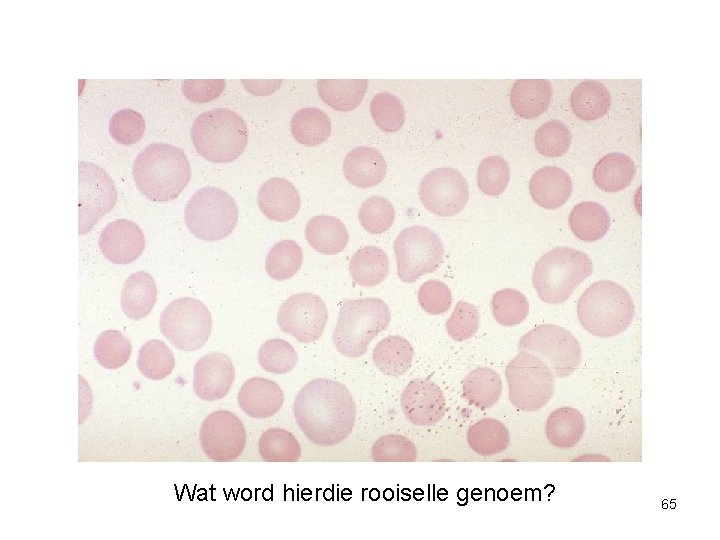
Wat word hierdie rooiselle genoem? 65

Beeldingsessie 1 Hematologie MBCh B V MJ Coetzee

Beeldingsessie 1 Hematologie MBCh. B V MJ Coetzee 1

Normale bloedbeeld 2

Normale bloedsmeer Normale witselle Normale rooiselle & plaatjies 3

Eosinofiel Basofiel 4

Normale stafsel 5

Normale beenmurg 6

• Stamselle gee aanleiding tot selle wat ontwikkel na volwasse selle in die sirkulasie • Probleme met stamselle veroorsaak beenmurg versaking en selfs leukemie 7

Normale beenmurgselle 8

Normale beenmurgsmeer Normale beenmurg partikel (1/3 vetselle) 9

Hipersellulêre beenmurg Biopsie (histologiese beeld) Partikel op smeer 10

Hiposellulêre beenmurg Vetselle het normale beenmurg vervang Been Aspiraat partikel 11

Volbloedtelling 12

Volbloedtelling-1 • Die VBT is ‘n group toetse wat ons inligting gee oor: – Rooiselle en hulle eienskappe – Totale witseltelling en konsentrasie van tipes witselle (differensiële telling) – Konsentrasie van plaatjies • ‘n Bloedsmeer word gemaak en die morfologie van die bloedselle gerapporteer • Dikwels word ‘n EBS tegelykertyd gedoen 13

Volbloedtelling -2 • Bloed vir ‘n VBT word in ‘n pers buis, wat die antistolmiddel EDTA bevat, getrek • Die buis behoort die lab. binne 2 ure te breik - anders kan artifakte ontstaan • Hand bloedtellings behels mondpipettering en is ‘n aansteeklikheidsrisiko • Ge-outomatiseerde seltellers tel rooiselle, witselle & plaatjies, en doen Hb en rooiselindekse 14

Hemoglobien-1 • Normale Hb varieër met ouderdom, geslag & hoogte bo seespieël • In Bloemfontein (1300 m) is die normale volwasse Hb: – Mans: 14, 5 -18, 5 g/dl – Vroue: 12, 5 -16, 5 g/dl 15

Hemoglobien-2 • Hb kan ook gemeet word in g/l en mmol/l • Wêreld Gesondheidsorganisie – By seevlak – Definisies van anemie (seevlak) deur deskundiges • Kinders < 10 j • Volwasse mans • Volwasse vroue • Swanger vroue < 9 g/dl < 13 g/dl < 12 g/dl < 11 g/dl 16

Rooiselindekse-1 • Die Hb toon die teenwoordigheid/ afwesigheid van anemie • Die rooiselindekse wys die tipe anemie • Die GKV (gem. korpuskulêre volume) is gewoonlik tussen 80 -100 fl – GKV < 80 fl: mikrositose – GKV 80 -100 fl: normositose – GKV > 100 fl: makrositose 17

Rooiselindekse-2 • Die hematokrit gee die gedeelte van die bloed wat gevorm word deur RBSe. – Dit word ekstensief in die VSA as ‘n aanduider van anemie gebruik, maar nie elders nie • Die GKH (gem. selhemoglobien) reflekteer die hoeveelheid Hb/RBSl • Die GKHK gee ‘n idee van die kleur van die RBSe • Deesdae word die GKV akkuraat gemeet en is dit meer belangrik 18

VBT lesing direk van selteller 19

Hematokriet 20

Witsel telling • Die totale WST is 4, 0 -11, 0 x 109/l • Meeste van die wit selle is neutrofiele • ‘n Leukopenie word meestal veroorsaak deur ‘n verminderde aantal neutrofiele, maar nie altyd nie • ‘n Leukositose word meestal veroorsaak deur ‘n verhoogde aantal neutrofiele, maar nie altyd nie • Dus is dit belangrik om die absolute telling van individuele tipes witselle te 21 bepaal

Verslag van die bloedsmeer • Alhoewel mens baie inligting van die VBT kan kry, lees altyd die kommentaar oor die bloedmorfologie • Hierdeur kan bv. malaria, links verskuiwing, geaktiveerde limfosiete, ens, opgetel word, terwyl meeste masjiene dit nie kan doen nie – Dit plaas die tellings in perspektief en lei mens om die oorsaak van ‘n anemie, ens. te bepaal 22

Rooiselvorms 23

Ronde makrositose (bv. alkohol) Ovaal makrosiete (bv. Megaloblastiese anemie 24

Akantosiete (bv. lewersiekte) Bloedsmeer Elektron mikroskopie 25

Polichromasie, bv. hemolise of bloeding Rouleaux (bv. TB, HIV) 26

Sferosiete: bloedsmeer Fatsoen van normale RBS & sferosiete 27

Teikenselle (bv. lewersiekte) 28

Algemene witselafwykings 29

Neutrofiele • Neutropenie – Meestal veroorsaak deur onderdrukking – Ook genoem agranulositose – Oorsake: antitiroïede, anti-inflammatoriese middels, antikonvulsante, antipsigotika, sitostatiese chemotherapie, bestraling – Gevolge: infeksies (veral. respiratories), opportunisies, fungi • Neutrofilie (neutrofiel leukositose) – Meestal veroorsaak deur bakterieële infeksies – Met erge infeksies kan hulle toksiese granulasie toon – ‘n Verskuiwing na links dui dat onvolwasse WBSe infeksie 30

Neutrofiel leukositose Toksiese granulasie 31

Stafsel (verskuiwing na links Döhle liggaampies (infeksie) 32

Leukoeritroblastiese anemie: Witsel & rooisel voorlopers 33

Leukoeritroblastiese anemie: beenmurg-infiltrasie deur kankerselle 34

Limfosiete • Limfopenie – Meestal veroorsaak deur middels, bv. steroïede • Limfositose – Meestal veroorsaak deur virale infeksie – Met erge virusinfeksies kan die limfosiete geaktiveerd voorkom 35

Die leukosiet in virale infeksie: reaktiewe limfosiet 36

Monosiete & eosinofiele • Monositose – Meestal veroorsaak deur chroniese infeksies, bv. TB • Eosinofilie – Parasitêre infeksies, allergieë, veltoestande, neoplasie 37

Stoor artefak (bloed wat rondlê) 38

Ander infeksies 39

Los kernfragmente HIV Suurvaste basille in beenmurg (TB) 40

Dik smere Malaria Falciparum trofosoïete Falciparum gametosiete (langstaande infeksie Nie-falciparum malaria (selle groot) 41

Geografiese gebiede van malaria - dus hemoglobinopatieë 2002 42

Fe-gebrek 43

Bleekheid “Strawberry” tong: Fe-tekort Hande nuttig, ongeag velkleur 44

Fe-gebrek: lepelnaels 45

Hipochroom mikrositêre RBSe 46

Normale (blou) Fe kleuring van murg partikel Geen Fe-kleuring in murg partikel nie 47

Gastrointestinale bloeding a. g. v. kanker (Ba-kontras) 48

Megaloblastiese anemie 49

Ovaal makrosiet Megaloblastiese BM 50

51

Vit B 12 gebrek: demiëlinisasie 52

Hemolitiese anemieë 53

Geelsug van hemolise 54

Warm (Ig. G) OIHA: sferosiete, polichromasie, normoblaste 55

Koue (Ig. M) outoimmuun hemolitiese anemie: agglutinasie Makroskopiese agglutinasie in bloedbuis 56

Meganiese hemolise (skistosiete) 57

Oorsake binne die RBS-membraan • RBS-sitoskelet onder fosfolipied-membraan – Komplekse mutasies • Oorerflike sferositose – Verskillende mutasies lei tot verlies van membraan (sokkerbal RBSe) • Rx: splenektomie Galstene na chroniese hemolise (barium in galblaas) 58

Oorsake binne die RBS • Ensiem-gebreke – G 6 PD-gebrek algemeen in Afrika • Hemoglobinopatieë – Talassemieë, sekel Hb • Infeksies – Malaria • Falciparum 59

60

• Aplastiese anemie: purpura van trombositopenie 61

• Fanconi anemie • Sister (L) is klein, het abnormale duime, café-au-lait kolle & ‘n inblywende kateter vir haar gereelde oortappings • Sister (R) normaal 62

Plaatjies • Trombositopenie – Verminderde produksie (beenmurgversaking) of vermeerderde afbraak (ITP) • Trombositose – Reaktief: infeksies, postsplenektomie – Trombositemie: essensiële trombositemie 63

Beskryf hierdie rooiselle asb. 64
Wat word hierdie rooiselle genoem? 65

Wat is die oorsaak van hierde rooiselverskynsel? 66

Wat is die naam van hierdie hemoglobinopatie? 67

Wat is die enkele oorsaak van al hierdie rooiselveranderinge? 68

• Papiergeval 1 • Anne is ‘n vyf-en-veertig jarige vrou wat prematuur grys is. Sy kla dat sy toenemend moeg geword het oor die laaste paar maande. Sy kan skaars ‘n blok loop. Sy het ook haar sin van balans verloor. By ondersoek is sy bleek, gering geelsugtig en het krake aan haar mondhoeke. Haar tong is rou en haar polse is vinnig. Sy het haar sin van vibrasie in haar arms en bene verloor. Haar volbloedtelling is as volg: witseltelling 2. 5 x 109/l (normaal 4 -11 x 109/l), hemoglobien 6 g/dl (normaal 12. 5 -16. 5 g/dl) en plaatjies 100 x 109/l (normaal 150 -400 x 109/l). Daar word gerapporteer dat haar rooiselle ovaal en makrositêr is. Die kerne van haar neutrofiele toon hipersegmentasie. 69

• Papiergeval 2 • Nick is ‘n 50 -jarige man wat voordoen met oefeningsinkorting. He eet ‘n redelik normale dieet. By ondersoek het hy ‘n boonste abdominale chirugiese litteken en hy sê hy het‘n gedeeltelike gastrektomie, vir ‘n bloeiede ulkus, gehad vyf jaar gelede. Sy volbloedtelling is as volg: witselle 4 x 109/l, hemoglobien 9 g/dl en ‘n plaatjies 100 x 109/l. Daar word gerapporteer dat hy ovaal makrosiete het. 70

• Papiergeval 3 • Mev Hester van Wyk is 30 jaar oud. Sy het drie kinders en is swanger met hulle vierde. Haar man het drie maande gelede sy werk verloor en hulle woon in Joe Slovo informele nedersetting. Sy voel toenemend moeg en kom na die Polikliniek. Sy sê sy word duiselig en kla dat haar hart baie vinnig klop. Sy het ‘n smaak vir kleigrond ontwikkel. • By ondersoek is sy bleek en het effens enkeledeem. Haar polssoed is 90/min. Sy is 30 weke swanger. Jy trek ‘n volbloedtelling en sien haar hemoglobien is 8 g/dl met ‘n gemiddelde selvolume van 65 fl. 71

Papiergeval-4 Tessa is an 18 -jarige meisie wat oor die afgelope twee weke moeg en bleek geword het. Die linker boonste gedeelte van haar buik is teer. Tessa se moeder sê dat Tessa se oë geel geword het. Haar moeder het ‘n soortgelyke toestand gehad toe sy ‘n jong vrou was en het ‘n splenektomie gehad. Daarna het haar moeder se simptome nooit haarhaal nie. Tessa se volbloedtelling is as volg: witseltelling is 7 x 109/l, hemoglobien 8 g/dl en haar plaatjietelling is 250 x 109/l. Haar bloedsmeer toon sferosiete en haar retikulosiettelling was verhoog. 72
- Slides: 72